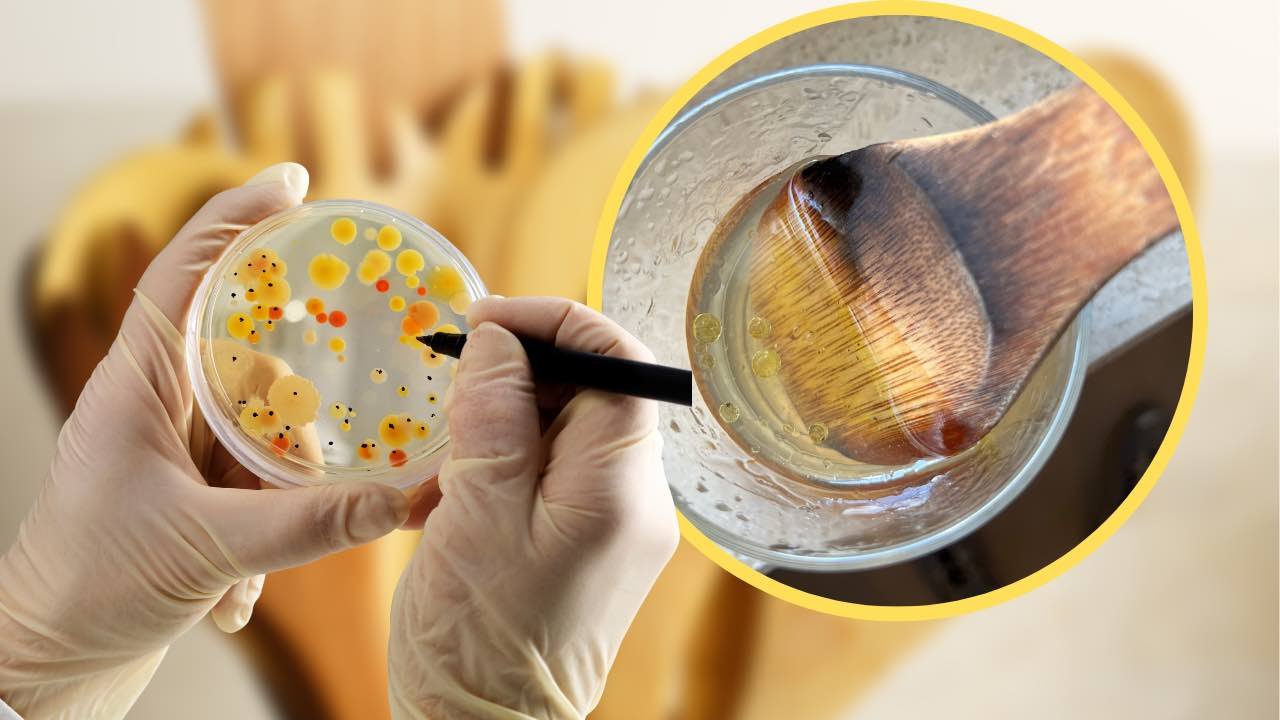

As louches em madeira, frequentemente chamadas de “cucchiarelle” em uma reverência à tradição, são uma presença constante nas cozinhas e são essenciais para misturar alimentos durante o cozimento. Além de serem usadas para molhos, elas são incrivelmente úteis na preparação de risotos, refogados, servindo como talheres para salada e até mesmo na confeitaria, para engrossar cremes e bater massas.
A escolha da louça de madeira é particularmente vantajosa, pois permite mexer pratos sem danificar panelas com revestimento de Teflon. No entanto, uma desvantagem é que com o tempo, elas tendem a escurecer, perdendo sua tonalidade clara e natural devido ao calor. Além disso, a superfície porosa da madeira tende a absorver substâncias, e se não forem limpas adequadamente após o uso, as bactérias podem proliferar.
Se medidas não forem tomadas imediatamente, os alimentos podem endurecer e grudar na louça, criando depósitos difíceis de remover. Uma maneira eficaz de limpar essas louches é através do método do copo, que, aparentemente, funciona muito bem.
Procedimento para Limpeza com o Método do Copo
Uma dica importante para limpar as louches de madeira é evitar o uso de detergentes, pois os produtos químicos podem penetrar nos poros da madeira e serem liberados nos alimentos. O método do copo é uma solução eficaz que não utiliza substâncias prejudiciais à madeira e é extremamente simples de executar. Veja como fazer:
- Escolha um copo ou xícara resistente ao calor: Certifique-se de que seja grande o suficiente para acomodar a parte superior da louça.
- Encha o copo com água quente a 90°C: Coloque a louça dentro do copo e deixe-a de molho por 5 minutos.
- Mexa a louça dentro do copo: Durante o tempo indicado, você verá a sujeira acumulada na louça começar a se dissolver e se depositar na superfície da água.
- Enxágue e seque: Após deixar a louça esfriar, enxágue-a com água limpa e seque-a completamente, removendo qualquer resíduo restante.
Outros Métodos Eficazes de Limpeza
Além do método do copo, existem outras maneiras eficazes de desinfetar louches de madeira utilizadas na cozinha:
- Bicarbonato de sódio: Ótimo para remover resíduos alimentares, basta umedecer um pouco de bicarbonato e esfregar vigorosamente nas áreas afetadas. Enxágue cuidadosamente e seque.
- Vinagre branco: Ferva dois copos de água com dois copos de vinagre branco e mergulhe as louches de madeira na mistura por 5 minutos. Após o tempo, enxágue e seque.
- Suco de limão: O limão pode ser esfregado diretamente na louça ou adicionado à água quente. Em seguida, deixe a louça secar ao sol, o que a desinfeta e a clareia.
- Sabo de Marseille: Dissolva alguns flocos de sabão de Marseille em água quente e use a solução para lavar a louça. Enxágue bem e seque.
Ao seguir esses métodos de limpeza e desinfecção, você garantirá que suas louches de madeira estejam sempre limpas e prontas para uso na cozinha, proporcionando refeições deliciosas com segurança.